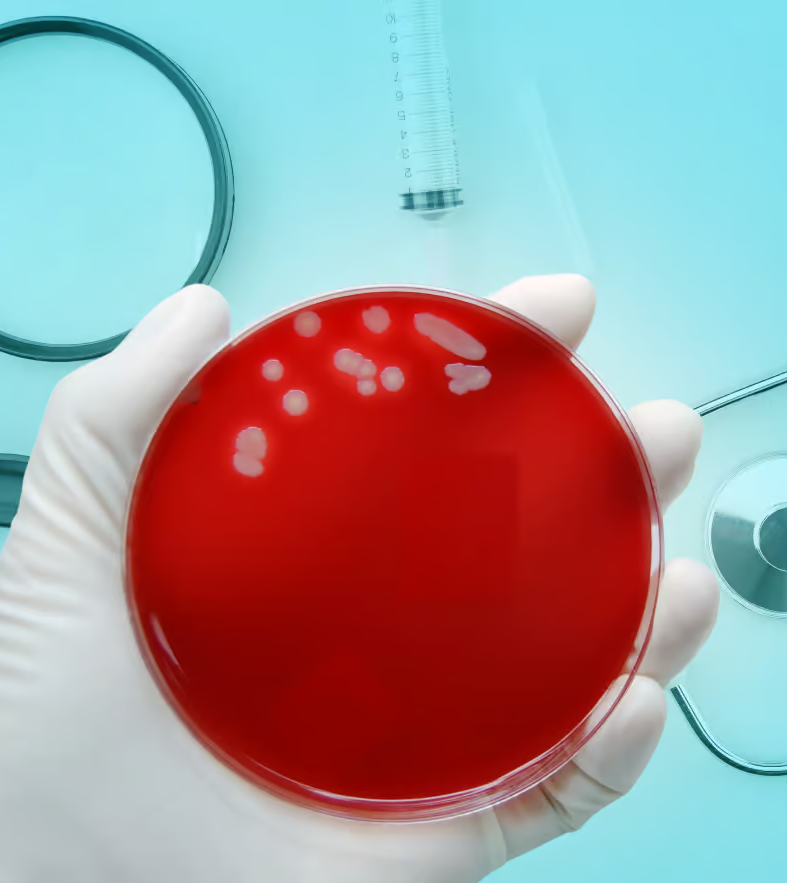
Gronkowiec złocisty MRSA Staphylococcus

Patroni Medialni: Klucz do sukcesu wydarzenia medycznego
Rozpoczynamy kolejny sezon pełen wydarzeń, kongresów, konferencji, szkoleń, eventów medycznych oraz nieustannej pracy na rzecz edukacji pacjentów. To idealny czas, aby przyjrzeć się roli Patronów...